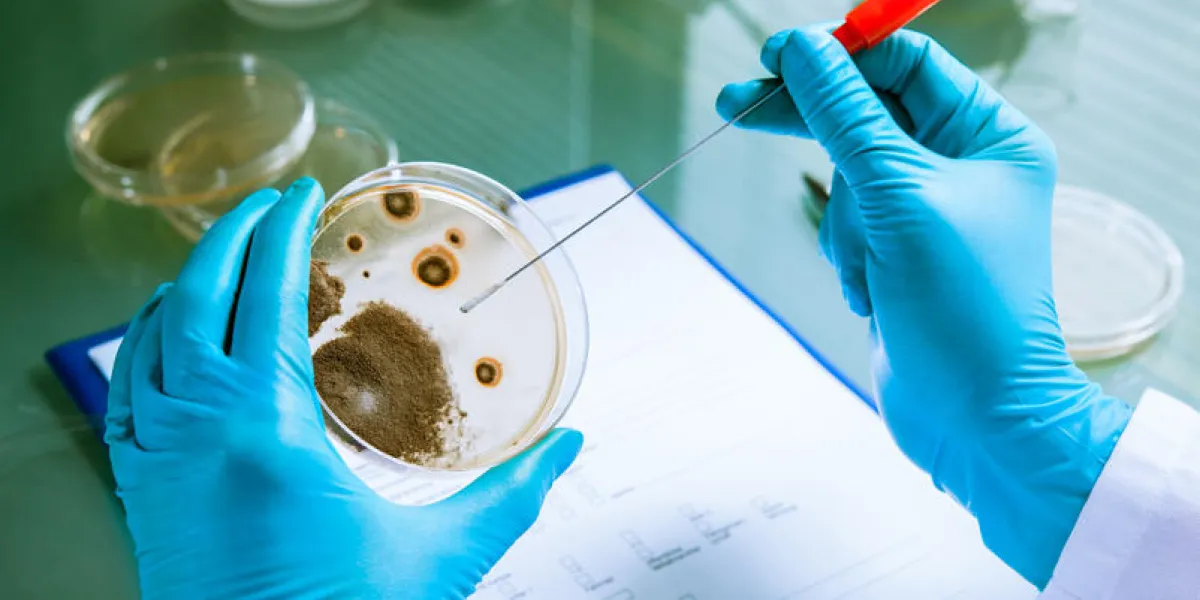
germs growing on an agar plate in laboratory

Covid : les vaccinés sont-ils plus contagieux que les autres ?
Faut-il craindre le vaccin anti-Covid ? En France, il inquiète un certain nombre de personnes, à en croire les larges mobilisations et regroupements qui s’organisent un peu partout sur le territoire hexagonal. Bon nombre de manifestants s’opposent à l’extension du pass sanitaire, qu’ils accusent (à juste titre, au moins d’un point de vue purement légal) de réduire leurs libertés individuelles. Mais ils ne sont pas les seuls à composer les rangs de ces multiples cortèges : parmi eux se dressent aussi des "antivax", pour "anti-vaccin", dont Planet publiait récemment le portrait-type.
Certains jugent le vaccin, peu importe d’où qu’il vienne, dangereux. Ils refusent donc de se le voir injecter, tantôt par crainte des éventuels effets secondaires qui pourraient accompagner le sérum, tantôt parce qu’ils estiment tout simplement que ce n’est pas nécessaire. Toujours est-il qu’une récente polémique a de quoi apporter de l’eau à leur moulin.
En effet, Outre-Atlantique, certains s’interrogent : avec l’émergence du variant Delta, faut-il craindre que les vaccins ne soient pas assez efficaces ? Jason Meister, membre du conseil consultatif de l’ancien président américain Donald Trump soulignait le risque, pour les individus affichant un parcours vaccinal complet de se montrer tout de même en mesure de contaminer d’autres personnes.
twitter.com/jason_meister/status/1420109166216110093
Covid-19 : est-on encore contagieux après s’être fait vacciner ?
L’ancien conseil présidentiel s’appuie sur le changement de directive du Centre de prévention et de lutte contre les maladies (CDC), indique Libération. Il s’agit de la principale agence fédérale de santé du pays, indiquent d’ailleurs nos confrères. Sa directrice, Rochelle Walensky, expliquait récemment avoir de nouvelles données disponibles sur le degré de contagiosité du variant ; lesquelles justifieraient le port du masque en intérieur dans les zones à risque pour les citoyens et ressortissants américains intégralement vaccinés.
Difficile, dès lors, de ne pas y voir un signe de la contagiosité supposée des vaccinés. Mais cela suffit-il à donner raison à Jason Meister et aux antivax ? Pas nécessairement…
Covid-19 : faut-il craindre les gens qui se sont fait vacciner ?
"Les personnes vaccinées pourraient présenter des niveaux plus élevés de contagiosité et infecter d’autres personnes avec la vague de contaminations provoquée par le variant delta", a écrit le quotidien USA Today, en s’appuyant sur les déclarations de Rochelle Walensky. C’est l’article qu’a relayé Jason Meister, poursuit Libération.
Seulement, cette lecture des conclusions du Centre de prévention et de lutte contre les maladies est inexacte, assurent encore nos confrères. Rien ne permet, en effet, d’affirmer que les individus vaccinés risquent davantage de transmettre le virus que les autres. Au contraire.
"Déclarer que ‘les vaccinés pourraient avoir des niveaux plus élevés de virus’ peut en effet être compris comme ‘plus élevé que cela n’était observé pour les autres variants’", observe d’ailleurs Libération, non sans souligner que USA Today a préféré supprimer le paragraphe litigieux de son article…
Ce n’est pas le seul point à retenir concernant la différence entre les individus vaccinés et les autres. Explications.
Covid-19 : les individus vaccinés sont contagieux bien moins longtemps
S’il est désormais établi que le vaccin n’empêche pas complètement de transmettre le virus, puisqu’il n’offre pas un niveau de protection de 100% contre ce dernier, il apparaît cependant évident qu’il diminue considérablement - et rapidement - la charge virale.
Concrètement, cela signifie donc qu’une personne vaccinée mais néanmoins porteuse du virus demeure contagieuse nettement moins longtemps qu’un vis-à-vis non-vacciné. En outre, il permet de briser les chaînes de contamination, ce qui contribue à protéger la population, au moins d’un point de vue collectif.
